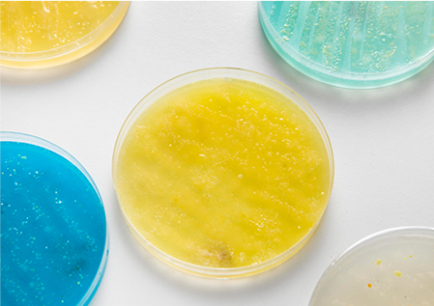
Jinan Zhongya Xincheng Import and Export Co., Ltd.

Intozhong Ya Xin Cheng
Establish good reputation in the industry with service, integrity and strong technical capability.Ji'nan China Ya Xin Cheng import and export trade Co., Ltd.,located in Shandong Ji'nan high tech Zone environmental protection and Technology Park, was established in December 2003, mainly engaged in chemical raw mater...

Main Products
chemical raw materials, raw materials, pesticide raw materials, various intermediate raw materials,
medical equipment and equipment

Cooperate
We sincerely welcome the patronage And cooperation of customers and Colleagues at home and
abroad.

- VR

Appearance: white or off-white crystalline powder, odorless, bitter taste. Deterioration in contact with light. Mp214-220°C (decomposition); Specific rotation [α] 25D+157.5° (dioxane), +176° (chloroform), +162°-+169° (ethanol); The ethanol solution has a maximum absorption at a wavelength of 242 nm…

Methylamine has a wide range of industrial uses. Monomethylamine can be used as a raw material for medicine (activation, caffeine, ephedrine, etc.), pesticides (carbaryl, dimethoate, amidine, etc.), dyes (alizarin intermediates, anthraquinone intermediates, etc.), explosives and fuels (hydroglue…

Boiling Point: 143-144 °C35 mm Hg(lit.)Density: 1.568 g/mL at 25 °C(lit.)Refractive index n20/D 1.572(lit.)Flash point > 230 °FSpecific gravity 1.568Sensitivity: Moisture sensitivityBRN4989077CAS DataBase Reference: 86393-34-2use2,4-Dichloro-5-fluorobenzoyl chloride is the main raw material for…

2,3,4,5-TETRAFLUORBENZOYLCHLORID2,3,4,5-TETRAFLUOROBENZOYL CHLORIDEBenzoyl chloride, 2,3,4,5-tetrafluoro- (9CI)2,3,4,5-Tetrafluorobenzoyl2,3,4,5-Tetrafluorobenzoyl chloride 98%2,3,4,5-TETRAFLUOROBEZOYL CHLORIDE2,3,4,5-Tetrafluorobenzoylchloride98%94-24-62,3,4,5-Tetrafluorobenzoic acid…

Appearance: Yellow needle-like crystals. Melting point 54-56 °c.Melting Point: 55-58 °C(lit.)Boiling Point: 83-84 °C (0.7501 mmHg)Density 1.13Vapor pressure 0.56Pa at 25°Crefractive index1.4500 (estimate)Flash point > 230 °FStorage conditions: 2-8 °CSolubility: Phthalendehyde at 20°C solubility…

Trehalose, also known as fenose and fungose, is a non-reducing disaccharide composed of two glucose molecules with the molecular formula C12H22O11 [8]. The structural formula of trehalose is α-D-glucopyranoside ~ α-D-glucopyranoside, which often exists as a dihydrate, and the molecular formula is…

Anilidine, also known as aminobenzene, is an organic compound, chemical formula C6H7N, is a colorless oily liquid, heated to 370 °C decomposition, slightly soluble in water, soluble in ethanol, ether and other organic solvents.Aniline is one of the most important amines. It is mainly used in the…

L-alanine is an natural compound with the system C3H7NO2, is a colorless to white crystalline powder, soluble in water, ethanol, insoluble in ether and acetone. It is commonly used in biochemical research, tissue culture, liver feature determination, taste enhancer, can expand the seasoning impact …

Rare earth chitosamine chelated saltsRare earth chitosamine integration salts are special compounds that are composed of rare earth elements and chitosamine formed integrators. In chemistry, integration refers to the combination of one or more coordination groups (usually dominated by oxygen and…

Chemical propertiesFormaldehyde and resorcinol react under alkaline conditions to form orange-red compounds, which are colorimetric at a maximum absorption wavelength of 460nm to detect low traces of formaldehyde in textile and clothing.Since resorcinol can undergo enol and ketone form tautomerism…
We will do better
If you have any suggestions, complaints or needs for us,
You can tell us by the right message that we will know and
contact you in the first place.
CONTACT US
You can tell us by the right message that we will know and
contact you in the first place.
- Chemical production workshopWe sincerely welcome customers and colleagues at home and abroad to patronize and cooperate with us.

2023-10-25
May 13, 2020. Pharmaceutical intermediate body fluorine customized. Pharmaceutical fluorine: colorless liquid. The melting point -42 ℃. Boiling point 85 ° C. Refractive index (ND20) 1.4650. Relators (D420) 1.024. Insuvenate in water and mixes with ethanol, ether, acetone, and benzene. Apineine
2023-10-25
April 23, 2020. Customized in the middle of Shandong Pharmaceutical. The so -called Shandong pharmaceutical intermediate is actually some chemical raw materials or chemical products for drug synthesis process. This kind of chemical product does not require the production license of drugs. It can be


2023-10-25
Medicine intermediate refers to a compound generated as an intermediate step in the process of synthetic drugs. It has high purity and activity, which can synthesize target drugs through further chemical reactions. Medicine intermediates are widely used in the pharmaceutical industry, covering

2023-10-28
I. Overview of chemical and pharmaceutical intermediatesChemical pharmaceutical intermediates are a very important part of the pharmaceutical industry, referring to raw materials or semi-finished products in the pharmaceutical industry. These substances undergo a series of chemical reactions to
2023-10-25
Intermediate production of chemical medicine is a work involving a large number of chemicals. If it is not managed and controlled correctly, it may bring serious risks and pollution to the environment. In order to reduce environmental risks in the production of chemical medicine, we need to improve


2023-10-08
Shandong is one of the important pharmaceutical production bases in the country, and the production production is relatively concentrated. The treatment of Shandong Pharmaceutical Intermediate waste is essential for protecting the environment, human health, and sustainable enterprise. This article



